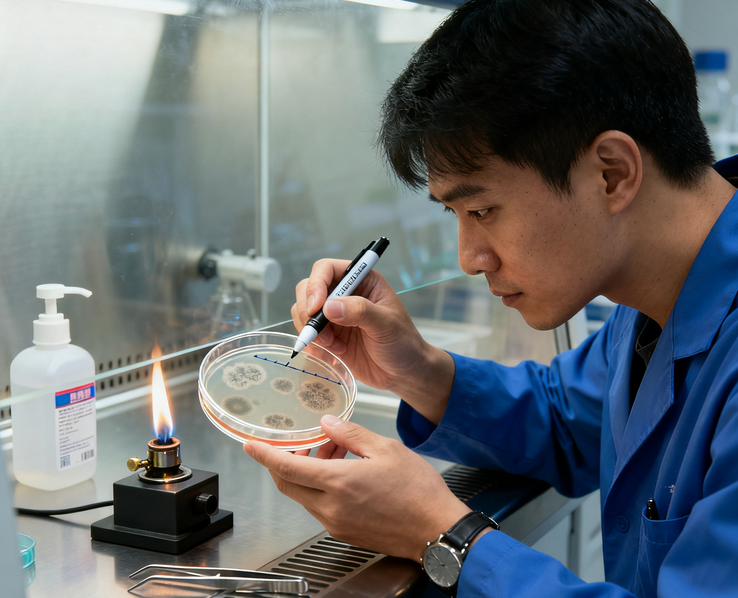

基因合成的完整实验流程包括哪些关键步骤?
基因合成的完整实验流程从序列设计到最终验证交付,需经过多个精准调控的关键步骤,核心是确保合成序列的准确性、完整性和功能性,具体流程如下:
一、序列设计与优化(源头控制)
目标序列获取与分析:明确合成基因的来源(如已知数据库序列、突变体设计或从头设计),核对序列长度、ORF(开放阅读框)完整性、酶切位点等关键信息,避免天然序列中的潜在问题(如重复序列、高GC含量区域)。
密码子优化(按需进行):根据目标表达宿主(如大肠杆菌、酵母、哺乳动物细胞)的密码子偏好性,调整密码子使用频率,同时避免引入二级结构(如茎环结构)或稀有密码子簇,提升后续表达效率(非表达用途可省略此步)。
酶切位点与标签设计:在基因两端或内部添加所需的限制性内切酶位点(便于克隆)、标签序列(如His-tag、Flag-tag,用于蛋白纯化或检测),确保添加序列不影响基因功能。
序列查重与二级结构预测:通过软件(如DNAman、SnapGene)检测序列中的重复片段、高GC/AT区域,预测可能形成的发卡结构或茎环结构,这些会阻碍合成效率,需通过碱基替换(不改变氨基酸序列)进行修正。
二、寡核苷酸合成(基础单元制备)
寡核苷酸(Oligo)设计与合成:将目标基因序列拆分为一系列短片段(通常40-60nt),相邻片段间存在15-20nt的重叠区域(便于后续拼接),由DNA合成仪通过亚磷酰胺法合成单链Oligo,合成后需脱保护、纯化(如HPLC或PAGE纯化,去除短片段杂质)。
Oligo质量检测:通过紫外分光光度计测定浓度和纯度(OD260/280比值需在1.8-2.0),必要时进行电泳检测,确保Oligo长度正确、无明显降解。
三、基因片段拼接(组装全长)
PCR拼接(主流方法):
重叠延伸PCR(OE-PCR):将所有Oligo混合,利用重叠区域互补配对,通过PCR扩增逐步延伸形成全长双链DNA;若基因较长(如>1kb),可先分段合成1-2kb的片段,再通过重叠区域拼接为全长。
酶促拼接:使用DNA连接酶(如T4DNA连接酶)或Gibson组装酶(可同时实现片段互补配对与连接),适用于多片段精准组装,尤其适合复杂序列(如含重复序列)。
拼接产物初步纯化:通过琼脂糖凝胶电泳分离目标长度的片段,切胶回收(避免非特异性扩增产物),或用PCR纯化试剂盒去除引物、酶等杂质。
四、克隆与扩增(载体连接与增殖)
载体选择与处理:根据后续用途选择合适载体(如克隆载体pUC19、表达载体pET系列),用限制性内切酶切割载体使其线性化,同时进行去磷酸化处理(防止载体自连)。
连接反应:将拼接后的全长基因与线性化载体通过DNA连接酶连接,形成重组质粒;连接体系需优化载体与插入片段的摩尔比(通常1:3-1:5),提升连接效率。
转化与筛选:将重组质粒转化至感受态细胞(如大肠杆菌DH5α),通过抗性筛选(如氨苄青霉素抗性)获得阳性克隆;挑取单菌落进行液体培养,扩增重组质粒。
五、序列验证(核心质控环节)
质粒提取:从阳性克隆菌液中提取重组质粒(小量提取用于初筛,大量提取用于精准验证)。
测序验证:通过Sanger测序(短基因)或二代测序(长基因或复杂序列)测定重组质粒的插入序列,与设计序列比对,确认无碱基错配、缺失或插入;若存在突变,需重新筛选克隆或修正拼接步骤。
酶切验证(辅助确认):用设计的限制性内切酶切割重组质粒,通过电泳检测酶切片段大小是否与预期一致,辅助验证插入方向和完整性。
六、交付与备份(最终环节)
产物制备:对验证正确的重组质粒进行大量提取、纯化(如endotoxin-free纯化,适用于细胞转染),测定浓度和纯度(OD值、电泳检测)。
交付形式:通常以质粒溶液(溶于TE缓冲液)或冻干粉末形式交付,同时提供测序报告、序列比对结果、浓度检测数据等质控文件。
备份保存:留存部分质粒或甘油菌(-80℃冻存),便于后续重复使用或验证。
整个流程的核心是通过多步质控(Oligo纯度、拼接产物长度、测序验证)确保合成基因的准确性,针对长片段或复杂序列(如高GC含量、重复序列),需在设计阶段和拼接步骤进行特殊优化,以提高成功率。
最新动态
-
10.27
多克隆抗体定制能否通过“分段设计抗原”实现对特定结构域的抗体富集?
-
10.27
多克隆抗体定制的采血方式与采血次数如何确定?
-
10.27
DNA合成的每一步偶联反应效率通常需达到多少才能保证全长产物比例?偶联效率低会导致DNA合成产物中出现哪些杂质?
-
10.27
酶促切割法进行siRNA合成的基本流程是什么?为何更适合制备siRNA文库?
-
10.27
基因合成的完整实验流程包括哪些关键步骤?
-
10.24
双荧光实验中用到的酶标板有什么特殊要求?
-
10.24
在微生物学研究中,酵母双杂交技术可用于研究哪些微生物相关的蛋白质相互作用,有何实际意义?
-
10.24
与凝胶迁移实验EMSA相比,酵母单杂交的优势和局限性在哪里?
-
10.24
免疫亲和法提取外泌体是如何实现的?
-
10.22
基因合成完成后,如何通过实验验证其序列的正确性?


